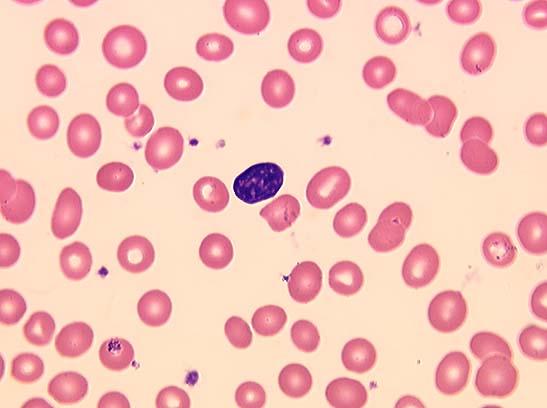

анизоцитоза
Анизоцитозата е състояние, при което в циркулиращата кръв се срещат различни по големина еритроцити.
Умерени вариации в размера на еритроцитите се срещат и у здрави лица – физиологична анизоцитоза.
За патологично променени по размер еритроцити се смятат тези, чийто диаметър е по-малък от 6.2 микрометра или по-голям от 8.2 микрометра.
В зависимост от преобладаването на големи или малки по размер еритроцити се различава съответно макро- или микроанизоцитоза.
Най-често анизоцитозата се дължи на наличието на различни по възраст еритроцити. Тя е един от важните признаци на анемията. Среща се при остри следкръвоизливни анемии, други анемии, левкоза, чернодробни заболявания, отравяния с олово и други.
Не е установена пряка зависимост между стойностите на MCV и анизоцитозата. Тя може да бъде съпроводена с ниски, нормални или повишени стойности на MCV.